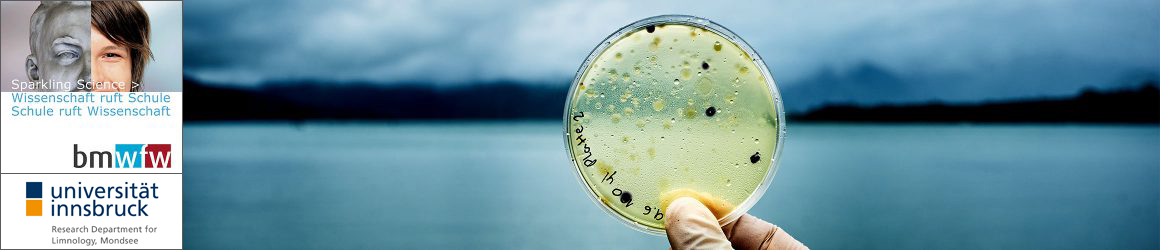

Verborgenen Welt der Bakterien:
Der Artenvielfalt der Bakterien
in heimischen Gewässern auf der Spur:
Isolierung und Beschreibung neuer Arten
Projekt am Forschungsinstitut für Limnologie, Mondsee der Universität Innsbruck unter der Leitung von Umweltmikrobiologe Assoz. Prof. Dr. Martin Hahn. Gefördert vom 1.9.2017 bis 31.12.2019 von Sparkling Science, eine Intiative des Bundesministerium für Bildung, Wissenschaft und Forschung, Österreich. Gemeinsam mit Schüler/innen aus sechs Oberstufenklassen Salzburger Gymnasien wurden neue Bakterienarten aus Gewässern der Umgebung isoliert und beschrieben.

